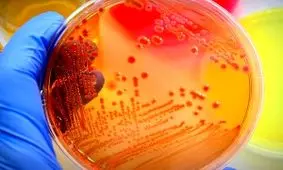
آسیب دیدن ریه ها به وسیله باکتری های دهان

سلامت ریه
-

فوق تخصص ریه:
آلودگی هوا عملکرد ریه را کاهش میدهد
یک فوق تخصص ریه با هشدار نسبت به پیامدهای آلودگی هوا بر دستگاه تنفسی، اعلام کرد: آلودگی هوا یکی از مهمترین عوامل…
-

۱۱ غذای برتر که التهاب ریه را کاهش می دهد
حفظ سلامت ریه برای سلامت کلی شما حیاتی است. قفسه سینه شما ممکن است پس از قرار گرفتن در معرض آلاینده ها از جمله دود…
-

چه مواد غذایی برای تقویت ریه و سیستم ایمنی بدن مفید هستند؟
متخصص تغذیه انستیتو تحقیقات تغذیهای و صنایع غذایی کشور نکاتی را درباره سبک تغذیه سالم و تقویت سیستم ایمنی در مقابله…
-

محققان اعلام کردند
استفاده از ماسک، تاثیری بر عملکرد ریه و قلب ندارد
یک محقق گفت: هیچ مدرکی مبنی بر وجود تفاوتهای جنسیتی یا سن در پاسخهای فیزیولوژیکی هنگام ورزش باوجود ماسک صورت وجود ندا…
-

رفتارها و عادتهایی که به ریه انسان آسیب میزند!/ اینفوگرافی
اگر میخواهید ریههایتان را سالم نگه دارید، باید بدانید چه رفتارها و عادتهایی به آنها آسیب میزنند تا از آنها…
-

بازیگری به بهای از دست دادن سلامت ریه؟ / بازیگر سریال پرطرفدار «پیکی بلایندرز» در هر فصل 1 هزار سیگار کشیده است
کیلین مورفی بازیگری است که بسیاری از مخاطبان او را به خاطر بازی در سریال پیکی بلایندرز میشناسند. اخیرا آماری در مورد…
-

بهترین غذاها برای داشتن ریه سالم و تنفس راحت
ریه یکی از مهم ترین اندام های داخلی است، بنابراین سلامت ریه اهمیت زیادی دارد که در ادامه خوراکی هایی معرفی می شوند که…
-
آسیب دیدن ریه ها به وسیله باکتری های دهان
سلامت دهان و دندان نه تنها به زیبایی صورت و خوردن غذای بهتر کمک می کند، بلکه سلامت دهان به طور مستقیم بر روی اندام های…
-

۱۰ هشدار که خبر از ضعیف شدن ریهها میدهد
کیفیت زندگی ما همواره به میزان مراقبت از بدن مان بستگی دارد، چون ارگان های درونی از اهمیت زیادی برخوردار هستند.
-

اثرات جانبی برخی داروها بر ریه فراتر از حد تصور است
تحقیقات محققان نشان میدهد بسیاری از داروها که به صورت مشترک و گسترده برای درمان آرتریت، سرطان و بیماری قلبی مورد…
